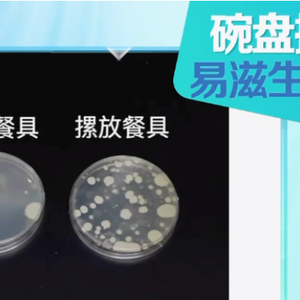

转自:河北青年报
刷碗这看似简单的事情
其实很有“技术含量”
很多人可能都“洗错”了!
一些坏的洗碗习惯
不仅不能把碗筷真正洗干净
反而会滋生细菌
影响健康,甚至致癌!
今天起
洗碗请务必调整一下
↓↓↓
擦碗布不更换:洗碗布和海绵用久不换,容易变成细菌、霉菌的藏身之处。
建议:最好一个月左右换一个洗碗布,并且洗碗布要专门用来洗碗。
洗涤剂直接涂碗上:一旦冲洗不干净,人体摄入洗涤剂后会引发腹泻等肠胃不适。
建议:戴上手套,将几滴洗洁精倒入水中,用洗碗布蘸着稀释后的水来刷碗,冲洗后放在另一个漏篮中,最后再用清水冲洗干净并晾干。
碗洗后摞着放:我们的碗筷或碗盘即使残留了一点点食物残渣,都可以作为细菌的营养物质。如果摞着放,积了很多水,房间温度又适宜,细菌就会疯长。
此前,家用电器研究院曾经做了一组试验——试验员先给餐具消毒,再在餐具表面涂上无菌肉汤,之后将餐具分为两组,其中一组碗盘清洗后直接摞起来放碗柜中储存,另一组洗后立着放于置物架上,并放于通风处。

三天后,结果显示:摞着放的餐具的菌落总数是立放组的70倍。
建议:清洗后,应将它们放在通风干燥的地方晾干,也可以使用干净毛巾或纸巾擦拭碗筷表面,加快晾干速度。
同时,要确保收纳碗筷的橱柜或收纳盒保持干燥和清洁。
餐具不消毒:长期不消毒餐具可能成为多种疾病的传播媒介,从急性肠胃炎到慢性癌症均存在风险。
建议:通过煮沸、蒸汽或紫外线定期消毒,并保持干燥存放,切断微生物滋生链。条件允许的话最好买一个消毒机,把碗筷放里面高温消毒。
转发,赶紧改掉这些习惯!
来源/CCTV生活圈
编辑/王丽